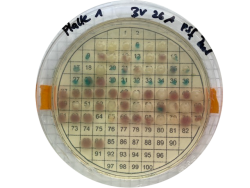
vibrio

Vibrio in marine habitats
contact: Prof. Dr. Matthias Labrenz

Background
Bacteria of the genus Vibrio are ubiquitous members of marine ecosystems. They occur in coastal, estuarine and brackish waters as well as sediments, often in association with higher organisms. Increased water temperatures lead to both, increased population densities of Vibrio spp. and the occurrence of potential pathogenic Vibrio species, which cause infections in (immunodeficient) humans (Ruppert et al., 2004). An infection with V. vulnificus, for instance, can result in sepsis with potential fatality. In recent years, multiple cases of severe wound infection and fatalities caused by V. vulnificus were reported in the Baltic Sea area. Within the scope of a monitoring program of the state Mecklenburg-Vorpommern, high Vibrio abundances were detected. Presumably, infections caused by members of the genus Vibrio will increase further in the light of climate change (Baker-Austin et al., 2013).
Research on Vibrio at IOW
In the project Vibrio - MV the reservoirs and diversity of regional populations of Vibrio spp. with focus on V. vulnificus in the coastal area of Mecklenburg-Vorpommern were investigated. According to this study, fish can serve as winter reservoirs for different Vibrio species, among them also the facultative pathogenic bacterium V. vulnificus. In particular, the invasive round goby (Neogobius melanostomus), may carry high Vibrio spp. cell counts (Möller et al., 2021). Bacteria of the genus Vibrio were also found in biofilms on microplastics (Zettler et al., 2013). Their possible role in this was investigated in the MikrOMIK project (Oberbeckmann et al., 2021).

Currently, we are investigating together with an international group of microbiologists, molecular biologists and marine ecologists from seven Baltic countries the influence of characteristic shallow water habitats such as seagrass beds, macroalgae or mussel beds on the diversity and abundance of Vibrio in the BaltVib project. Recent data suggest that in some of these habitats the abundance of pathogenic Vibrio spp. is reduced (Reusch et al., 2021). From this project, we expect to gain new insights into the regulating effects of these selected habitat types and abiotic environmental factors on the distribution and pathogenicity of Vibrio along the salinity gradient of the Baltic Sea. This knowledge will be used for management plans by national responsible authorities to conserve or expand these habitats and their associated beneficial ecosystem functions.